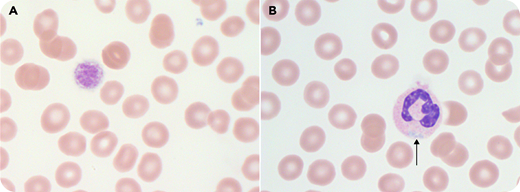
A 17-year-old girl presented with thrombocytopenia and menorrhagia. Her mother, maternal grandfather, and uncle also had thrombocytopenia. Peripheral counts revealed a platelet count of 88 × 109/L with unmeasured mean platelet volume. The peripheral blood smear (panels A-B; original magnification ×100; Wright-Giemsa stain; normocytic red blood cells provide scale) demonstrated giant platelets in every other high-power field (panel A) and neutrophils with type I Döhle-like inclusions (panel B). A von Willebrand factor profile was normal. Targeted gene sequencing confirmed a pathogenic heterozygous missense mutation in myosin heavy chain 9 (MYH9) (NM_002473.5:c.3493C>T (p.Arg1165Cys); rs80338829). Menorrhagia was caused by dysfunctional uterine bleeding, and it resolved with tranexamic acid. This case highlights the role of microscopy in the evaluation of thrombocytopenia.

A 17-year-old girl presented with thrombocytopenia and menorrhagia. Her mother, maternal grandfather, and uncle also had thrombocytopenia. Peripheral counts revealed a platelet count of 88 × 109/L with unmeasured mean platelet volume. The peripheral blood smear (panels A-B; original magnification ×100; Wright-Giemsa stain; normocytic red blood cells provide scale) demonstrated giant platelets in every other high-power field (panel A) and neutrophils with type I Döhle-like inclusions (panel B). A von Willebrand factor profile was normal. Targeted gene sequencing confirmed a pathogenic heterozygous missense mutation in myosin heavy chain 9 (MYH9) (NM_002473.5:c.3493C>T (p.Arg1165Cys); rs80338829). Menorrhagia was caused by dysfunctional uterine bleeding, and it resolved with tranexamic acid. This case highlights the role of microscopy in the evaluation of thrombocytopenia.
MYH9-related disorders (MYH9-RDs) are rare with autosomal dominant inheritance. They result from defects in nonmuscle myosin heavy chain class IIA, which disrupts maturation and fragmentation of megakaryocytes, thus causing macrothrombocytopenia. Döhle-like inclusions are blue intracytoplasmic accumulations of myosin heavy chains within granulocytes; type I and II inclusions can be seen on Wright-Giemsa–stained blood smears. MYH9-RDs include May-Hegglin anomaly, Sebastian platelet syndrome, Fechtner syndrome, and Epstein syndrome. Bleeding is uncommon with a platelet count >50 × 109/L. MYH9-RD may be associated with end-stage renal failure, presenile cataracts, and progressive sensorineural hearing loss, so hematologists play a vital role in its identification.
A 17-year-old girl presented with thrombocytopenia and menorrhagia. Her mother, maternal grandfather, and uncle also had thrombocytopenia. Peripheral counts revealed a platelet count of 88 × 109/L with unmeasured mean platelet volume. The peripheral blood smear (panels A-B; original magnification ×100; Wright-Giemsa stain; normocytic red blood cells provide scale) demonstrated giant platelets in every other high-power field (panel A) and neutrophils with type I Döhle-like inclusions (panel B). A von Willebrand factor profile was normal. Targeted gene sequencing confirmed a pathogenic heterozygous missense mutation in myosin heavy chain 9 (MYH9) (NM_002473.5:c.3493C>T (p.Arg1165Cys); rs80338829). Menorrhagia was caused by dysfunctional uterine bleeding, and it resolved with tranexamic acid. This case highlights the role of microscopy in the evaluation of thrombocytopenia.
MYH9-related disorders (MYH9-RDs) are rare with autosomal dominant inheritance. They result from defects in nonmuscle myosin heavy chain class IIA, which disrupts maturation and fragmentation of megakaryocytes, thus causing macrothrombocytopenia. Döhle-like inclusions are blue intracytoplasmic accumulations of myosin heavy chains within granulocytes; type I and II inclusions can be seen on Wright-Giemsa–stained blood smears. MYH9-RDs include May-Hegglin anomaly, Sebastian platelet syndrome, Fechtner syndrome, and Epstein syndrome. Bleeding is uncommon with a platelet count >50 × 109/L. MYH9-RD may be associated with end-stage renal failure, presenile cataracts, and progressive sensorineural hearing loss, so hematologists play a vital role in its identification.
For additional images, visit the ASH Image Bank, a reference and teaching tool that is continually updated with new atlas and case study images. For more information, visit http://imagebank.hematology.org.
This feature is available to Subscribers Only
Sign In or Create an Account Close Modal